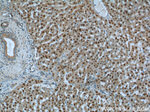
ONECUT1 Antibody in Immunohistochemistry (Paraffin) (IHC (P))

Search
Proteintech
ONECUT1 Polyclonal Antibody
{{$productOrderCtrl.translations['antibody.pdp.commerceCard.promotion.promotions']}}
{{$productOrderCtrl.translations['antibody.pdp.commerceCard.promotion.viewpromo']}}
{{$productOrderCtrl.translations['antibody.pdp.commerceCard.promotion.promocode']}}: {{promo.promoCode}} {{promo.promoTitle}} {{promo.promoDescription}}. {{$productOrderCtrl.translations['antibody.pdp.commerceCard.promotion.learnmore']}}
产品信息
25137-1-AP
种属反应
已发表种属
宿主/亚型
分类
类型
抗原
偶联物
形式
浓度
规格
纯化类型
保存液
内含物
保存条件
运输条件
产品详细信息
Immunogen sequence: PYHKDVAGM GQSLSPLSSS GLGSIHNSQQ GLPHYAHPGA AMPTDKMLTP NGFEAHHPAM LGRHGEQHLT PTSAGMVPIN GLPPHHPHAH LNAQGHGQLL GTAREPNPSV TGAQVSNGSN SGQMEEI (167-292 aa encoded by BC140830 )
靶标信息
Hepatocyte nuclear factor 6 is a CUT homeobox family protein which is a transcription factor and contains a CUT DNA-binding domain and a homeobox DNA-binding domain. It is an upstream regulator of several genes involved in the pathogenesis of maturity-onset diabetes of the young. HNF6 is a ligand of the FOXM1 transcription factor network. HNF6, along with HNF4, controls gene expression in the liver. The expression levels of HNF6 and HNF4 rise steadily during development and that up- or down regulation of HNF6 and HNF4 expression generate premature or delayed expression of the g6pc gene.
仅用于科研。不用于诊断过程。未经明确授权不得转售。
生物信息学
蛋白别名: hepatic nuclear factor 6; Hepatocyte nuclear factor 6; hepatocyte nuclear factor 6, alpha; HNF-3/forkhead homolog 12; HNF-6; One cut domain family member 1; One cut homeobox 1; transcription factor
基因别名: D9Ertd423e; Hfh12; HNF-6; HNF6; HNF6A; Hnf6b; OC-1; Oc1; ONECUT1
UniProt ID: (Human) Q9UBC0, (Mouse) O08755
Entrez Gene ID: (Human) 3175, (Mouse) 15379